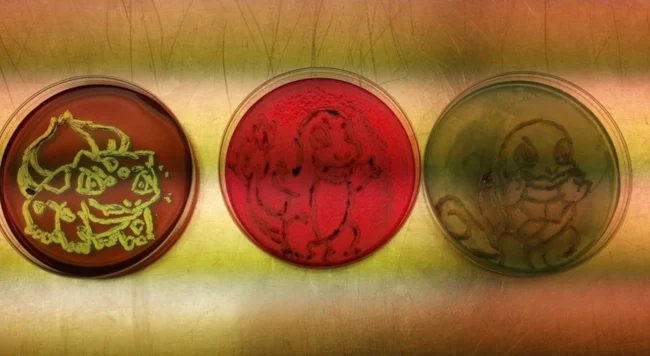

20 людей, которые выполняют свою работу на отлично (24 фото)
Эта подборка посвящена людям, которые выполнили работу от души, на 101%. Не надрываясь, но отдавая частичку себя. 
1. Это не входит в обязанности уборщицы, но почему бы и нет? 
2. Иранский учитель младших классов пришел к своему больному ученику, чтобы рассказать тему урока 
3. Парамедики не только отвезли мать троих детей в больницу, но и вымыли её посуду — ей пока не до этого 
4. Для сотрудника магазина расстановка товара уже стала как медитация и искусство постижения дзен 
5. Политика возврата товара рассчитана на 45 дней, но в магазине согласились принять вещь спустя 17 лет после покупки! 
6. Народный французский луковый суп подается в огромной луковице — фишка ресторана 
7. Хороший учитель математики поможет детишкам поверить в магию Рождества 
8. В мире пандемия коронавируса и завтрак в номер в отеле выглядит вот так — продукты, плюс тостер, плюс нераспакованная емкость с молоком 
9. Перфекционисты танцуют и аплодируют вприсядку! 
10. Шапочка закрывает волосы от продуктов и сотрудница фаст фуда решила не ограничиваться формальной кепкой 
11. Дело было вечером, делать было нечего 
12. Его оставили присмотреть за собакой и он присылает фотоотчеты о том, как работает 
13. Лаборант-биолог нарисовал в чашках Петри монстров из посевного материала бактерий
14. Зная о неуклюжести клиента, официантки клеят ему безопасные полоски, чтобы не проливал напиток 
15. Под путями проложены туннели для черепах и прочей живности, чтобы не гибла почем зря 
16. По дороге на работу учительница спасла котенка и не выпускала его из рук 
17. Артефакт в музее, память о всех погибших пожарных 
18. Не только красиво, но и удобно для администрирования 
19. Раз в год библиотекарь наряжается как смерть, чтобы собрать не сданные книги 
20. Когда постоялец попросил номер в отеле с бонусом, в виде принта на подушку с ликом Николаса Кейджа, он даже не ожидал, что они так сделают 


Он трудился на самой низкооплачиваемой работе, но все равно сумел заработать на первый взнос в колледж 






























